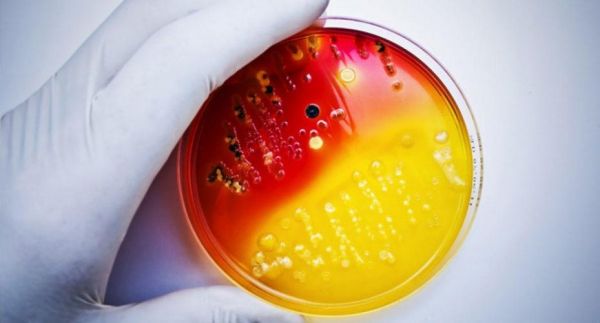
1650876701120772.png

抗菌加持减负,助力“清”松书包背负体验
近年来,升学焦虑与教育资源分配等相关话题引起社会热议。繁重的课业和多样化的辅导班成为了学生与家长们普遍面临的困境。据相关数据,三年级以下学生书包普遍重达3公斤,四年级多在4公斤左右,而仅五六年级学生的书包足足有5公斤以上。为让教育返璞归真,真正落实“德智体美劳”全面发展,国务院于2021年7月正式下发文件,提出“双减”教育目标,致力于减轻学生作业负担,健全作业管理机制,提高作业设计质量。去年10月更是拟将“双减”政策明确入法,尝试在“个人发展”与“唯成绩论”的“独木桥”之间取得平衡。

当下,“双减”政策有序落实,在减轻儿童青少年学业负担的同时,身体的健康发展与成长也是目前教育行业、与学生家长群体普遍关注的重点。书包作为常伴学子左右的必备物品,其用材质量、附加功能是消费者普遍关心的重点。CAMS作为推出国内市场首款AAA级抗菌悬浮减重书包品牌,通过对于力学、人体工程学与轻量化设计的长期研究,致力于减轻儿童青少年“负重”前行的压力,保障其回归健康形体。经国家重点实验室检测,该系列背包产品可有效将背负重量减重30%,尤其为学生人群带来更加轻松的书包背负体验,实现科学减重护脊。

相关医学研究表明,相较于成人,青少年体内由于有机成分和水分更多,脊椎抗压、抗弯能力相较而言更差。长期背负沉重的书包将影响儿童青少年的生长发育,可能导致骨骼弯曲,甚至引发脊柱侧凸疾病。目前,市面上大部分护脊书包仅通过改良背幅以达到提升背负舒适感的目的,治标不治本。为了帮助儿童青少年实现不再“负重”的目标,CAMS历经10年,对其产品进行数千次改进与测试,获得多项国家专利,最终具备有效减重30%功能的系列产品于2020年面世。CAMS独有的专利悬浮减重系统通过弹性势能的蓄能释能过程,将重力释放,大大降低肩膀所承受的平均负荷(感受重量)。这从根本上降低了青少年书包背负重量,为青少年生长发育、体态健康保驾护航。

“抗菌”与“减重”双剑合璧
在抗疫常态化的今天,消费者对微生物有了更加全面、科学的认知,公众的卫生、清洁意识也大幅度提升。抗菌清洁不再是先锋思想,而逐渐成为一种生活习惯。
微生物在生活的方方面面随处可见,尤其是纺织品,频繁的接触及外部环境的暴露使纺织品表面附着多种微生物,有些微生物还可能破坏织物表面,导致污渍、异味或加速产品降解。以书包为例,鉴于其长期暴露于人流密集环境的特点,增加书包表面接触多种微生物的可能性,极易导致书包产生污渍和异味。将具备抗菌功能的纺织面料应用于书包生产中可快速、有效缓解这一难题。尤其针对儿童青少年,其作为易感人群,对生活环境洁净、抑菌、安全的需求更高,具有抗菌功能并且长效保持清洁的书包无疑是更好的选择。
为进一步帮助公众满足生活长效洁净的需求,为学子带来轻便耐用的优秀产品,CAMS与全球内建抗菌技术和气味控制解决方案专家妙抗保®合作,共同携手为儿童青少年打造既能减重护脊又能提供全天候长效抗菌功能的书包,致力为学子们提供更安心的学习生活。
CAMS与妙抗保®针对中国市场需求,经过多轮沟通协调与研发测试,双方最终成功推出抗菌悬浮减重书包系列,为莘莘学子带来具有更佳体验感的产品。在妙抗保®“黑科技”创新抗菌技术逸洁师(AEGIS®)的支持下,CAMS旗下兼备减重护脊与抗菌防护功能的悬浮减重书包达到了FZ/T 73023-2006的AAA级抗菌标准,并在水洗50次之后依旧保有抗菌效果,确保书包全天候持续对微生物抑制。
阳离子抗菌剂AEGIS®:由内而外守护洁净
妙抗保®逸洁师(AEGIS®)微生物层是保证书包表面全天候洁净的关键要素。它是一种全方位的液体抗菌剂,其阳离子通过与维持细胞壁完整所需的细胞蛋白质相互作用,吸引微生物的细胞壁,并抵消细胞壁的天然防护。当逸洁师(AEGIS®)应用于产品表面时,会形成一种无色、无味、带正电荷的聚合物,该聚合物会吸引微生物的负电荷细胞膜,将其电击并破坏,最终会导致微生物细胞的分解(也称溶解),以此去除异味、污渍并防止产品过早分解。
妙抗保®逸洁师(AEGIS®)不仅仅适用于纺织面料,还能够被灵活应用于包括泡棉在内的多种产品表面。相较于其他微生物抑制化学杀菌剂,其不会导致产品表面损坏或褪色,也不会对生物体产生毒性或对环境带来负面影响。在保证抗菌有效的同时,经过逸洁师(AEGIS®)处理的CAMS悬浮减重书包还具有以下优势:
- 抗菌技术在生产阶段融入产品中,抗菌保护可保持超过50次一般家庭洗涤。足以覆盖产品的正常使用寿命。
- 所使用的抗菌技术经国内外多所实验室认证,且拥有长期安全使用记录。
- 经认证的抗菌技术持久耐用。
- 抑制产品中与表面上微生物的生长繁殖。避免由于微生物繁殖带来的污迹、异味、及产品老化等。
- 经强化产品在洗涤后,能帮助延长洗涤效果的有效性,提供更高级别的清洁防护。
CAMS副总裁赵国宏分享:“秉持提供轻松舒适背负体验的理念,历经十年研发,最终迎来这款革命性创新的书包面市,因其同时具备AAA级抗菌与悬浮减重护脊功能,满足了家长对于儿童产品在健康及抗菌防护方面更高的要求,因此受到了诸多学生家长的喜爱。后疫情时代,我们洞察到消费者卫生及抗菌意识空前提升,消费者对抗菌防护类创新产品的需求也在随之增长,未来我们期待与妙抗保®一同创造更多抗菌功能产品。”
妙抗保国际总裁Michael Ruby先生表示:“洁净生活是如今人们非常关心的话题,历经40余年的行业探索,我们很高兴看到妙抗保的技术与理念被越来越多行业广泛接受。我们期待未来能开发更多高附加值的创新技术,携手更多行业伙伴,共同赋能消费者生活的各个领域,推动人们生活的高质量发展。”
关于CAMS
CAMS品牌隶属广东瑞泰健康科技有限公司,是先进的健康产业研发设计与相关产品供应商。公司秉承“新轻年,不负重”的品牌理念,致力以匠心精神不断创新,为消费者提供更轻松、舒适的出行体验。
相关知识
康巴赫第五代抗菌蜂窝锅重磅来袭,全新升级五味俱全
松堡王国全新“3+6+2”战略 助力终端转型发展
快讯 | 林氏木业2021年开超700家门店,今年持续为供应商减负
松堡王国加盟电影《音爱而生》,助力家风传承
大金携手CIAA参编抗菌标准, 助力健康产业规范建设
喜临门全国大促火热来袭 双核抗菌新品床垫助国人“睡出免疫力”!
施彩科技:助力碳中和,为地球“减负”
旧房改造如何更健康 福力得净醛·抗菌地板来助力
Garbelotto环保地板|健康卫士,有效抗菌
好租818企业减负焕新季钜惠来袭 好房精选低至5折
推荐资讯
- 1起底明园集团:李松坚与凌菲菲 6469
- 2北京房地产市场调控政策出乎意 5371
- 3华为全屋智能AWE2024前 4763
- 4价格亲民的窗帘品牌推荐,高性 4584
- 52025最新窗帘十大品牌排名 4197
- 6北京“国补”新增4类智能家居 4104
- 7为什么进户线要用铝线 4037
- 8杯子送人有何忌讳吗 男人送女 3804
- 9海南: 多孩家庭租房每月提取 3466
- 10用心服务筑就每一份美好 3429
